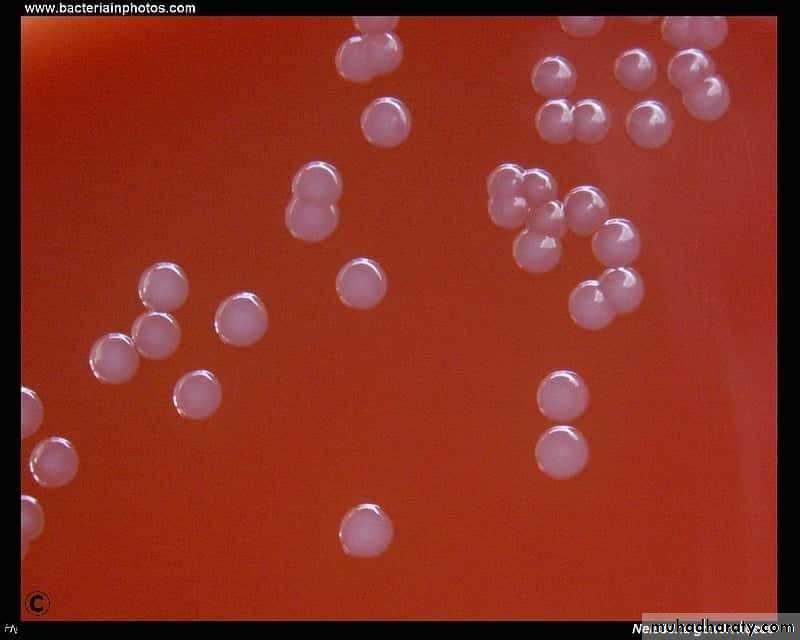
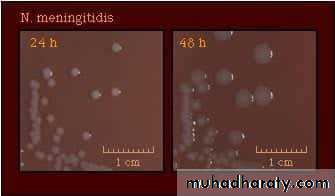
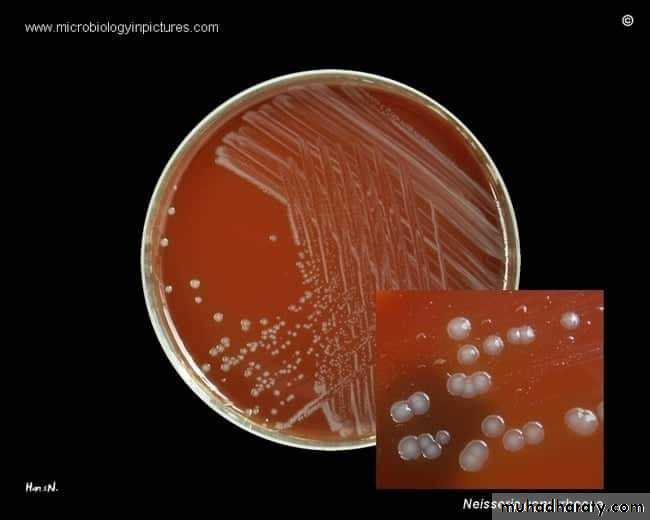
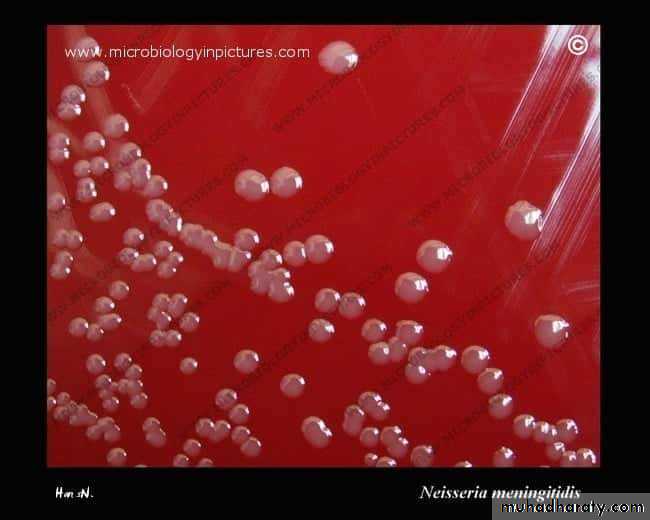
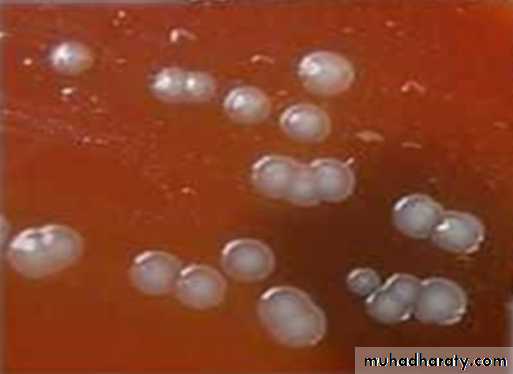
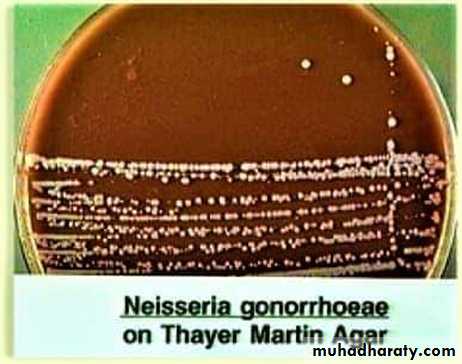
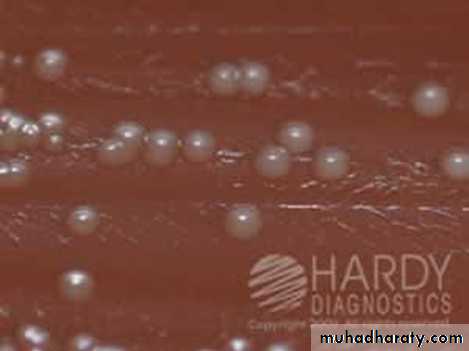
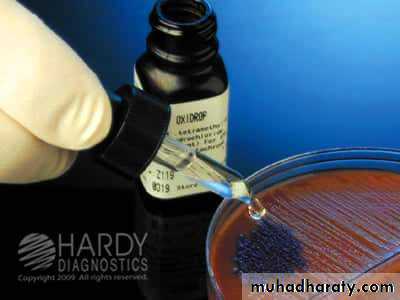

Genus Neisseria
This genus contains two important pathogenic species :
1. Neisseria meningitidis ( meningococcus ) causes cerebrospinal meningitis in man.2 . Neisseria gonorrhoeae ( gonococcus ) causes gonorrhoea in man.
MICROSCOPICAL APPEARANCE :
** Gram ( -ve ) bacteria, arranged in pairs measuring ( 0.6 – 0.8 ) µm in diameter.
** The cocci are generally kidney shape with flat or concave adjacent sides ( the long axis's are parallel ),
non motile and non sporing.
** They may be appear intracellular ( inside pus cell ) or extracellular.
Neisseria meningitidis in
CSF with associated PMNs** Electron microscope of Neisseria gonorrhoeae showing hair like filamentous appendages extend several micrometers from the cell surface.
** Electron microscope of Neisseria meningitides showing surface blebs.
Neisseria gonorrhoeae showing filamentous
Neisseria meningitidis showing blebs
CULTURAL CHARACTERISTICS :
** Aerobic, require ( 5 – 10 ) % CO² for primary isolation.** They are fastidious so they need enriched media ( e.g. blood agar, chocolate agar and Thayer - Martin agar ).
** The colonies are small, gray and transparent.
** Older colonies are larger with opaque raised center and thin transparent margin, no haemolysis on blood agar.
** Thayer - Martin agar is contain chocolate agar with antibiotics : Colistin, Vancomycin, Nystatin, Trimethoprim and is a selective and enriched medium for the isolation of Neisseria gonorrhoeae and Neisseria meningitides.
BIOCHEMICAL ACTIVITIES :
A. Oxidase test :All species produce oxidase enzyme (oxidase test positive ), this test is used in differentiate of Neisseria species from Gram +ve cocci.
Method :
A freshly prepared 5 % solution of Kovac´s oxidase reagent ( tetramethyl – p – phenylenediamine ) is poured in to the colonies, ( contain oxidase enzyme oxidizes the Kovac´s oxidase reagent into indophenols : purple color end product), when the enzyme is not present, the reagent remains reduced and is colorless.
B . Sugar fermentation :
It is used to differentiate pathogenic species from commensals.** The medium used contains serum to enhance the growth of pathogenic species, single carbohydrate such as glucose, lactose, sucrose, etc… and pH indicator such as Phenol red.
** Positive = yellow color is produced due to color change of phenol red.
** Negative = red color.